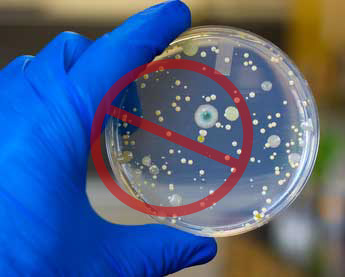

1950 Clinton St
Toledo, Ohio 43607
419.244.6555
Asbestos, Mold and Lead Abatement Specialists
Providing Quality Service Since 1998
1950 Clinton St
Toledo, Ohio 43607
419.244.6555
Mold
Do you have mold?
Mold comes in many colors and you can find it in many places in your home. Mold requires moisture to grow and a food source such as wood, paper, carpet and foods to feed on. Mold typically grows in wet or damp areas indoors. You will find mold in a crawl space, basement, attic, under sinks, showers and any other areas in your home with a moisture source.
Health Effects and Symptoms
If your home has mold in it you may start to smell the odors it can give off or find those living in the home to start having some health effects caused by the mold. Some of the health effects can be as simple as a headache or having symptoms such as breathing difficulties, skin irritations and allergic reactions. Contrary to popular belief black mold isn’t the only type of mold that causes these health effects. All molds have the potential to cause health effects. Even if the mold is dormant or has been killed off but is still in your home it can remain allergenic. For more on the health effects caused by mold please visit the Environmental Protection Agency’s website for mold. www.epa.gov/mold
Mold Prevention
Reducing the humidity in your home below 60% is a great start to prevent mold from growing in your home. Having proper ventilation in your home is also important to assist in the prevention of mold. Such things as bathroom vents should be vented to the outdoors and not into your attic. Making sure your downspouts around your home are draining away 36” or more from your foundation. Keeping proper ventilation in your basement, crawl space and attics helps prevent the growth of mold. Total Environment Services (TES) can help you to prevent mold growth in your home.
What To Do
When you find mold in your home or you would like to know if you have mold in your home you can call Total Environmental Services (TES). If you know you have mold in your home TES will come out to give you a proposal to remediate the mold. If you are not sure if you have mold we will send out one of our inspectors to inspect for mold and do a formal assessment for you. We will also do air or bio-tape sampling for you if requested. Our air samples are sent to an independent 3rd party lab for testing. The results will be supplied in the formal assessment with an explanation of the results found.
Total Environmental Services: Mold Remediation
When Total Environmental Services comes to your home for mold remediation we will use our proven method to kill the mold, remove it and prevent it from returning. In all cases we place the affected area under a negative air containment using an AFD (Air Filtration Device or sometimes called Air Scrubbers). This is accomplished by closing off all open air sources except one to be used as our make-up air. The AFD will draw in any particles that are floating in the air before and during the remediation process. The air then is filtered to 99.9% clean and dispersed back into the room. As part of the containment a 6 mill vapor barrier will be laid down to accumulate the falling mold. Once the room is under containment TES will kill the mold using ‘Shockwave’. Once Shockwave is applied the affected areas will then be scrubbed with nylon brushes as to not damage any surfaces and then wiped down with rags to remove any missed by the brushing. Then the surfaces are swept up using a HEPA filter vacuum to clean up the excess debris. Once all this is complete and the area is dry TES will apply the mold preventer IAQ6100 which dries clear and protects the surfaces from future mold growth.
Total Environmental Services -
Mold Remediation Process:
- Assess your mold issue
- Develop a removal plan specific
to your needs
- Kill and remove all mold
- Prevent future mold problems